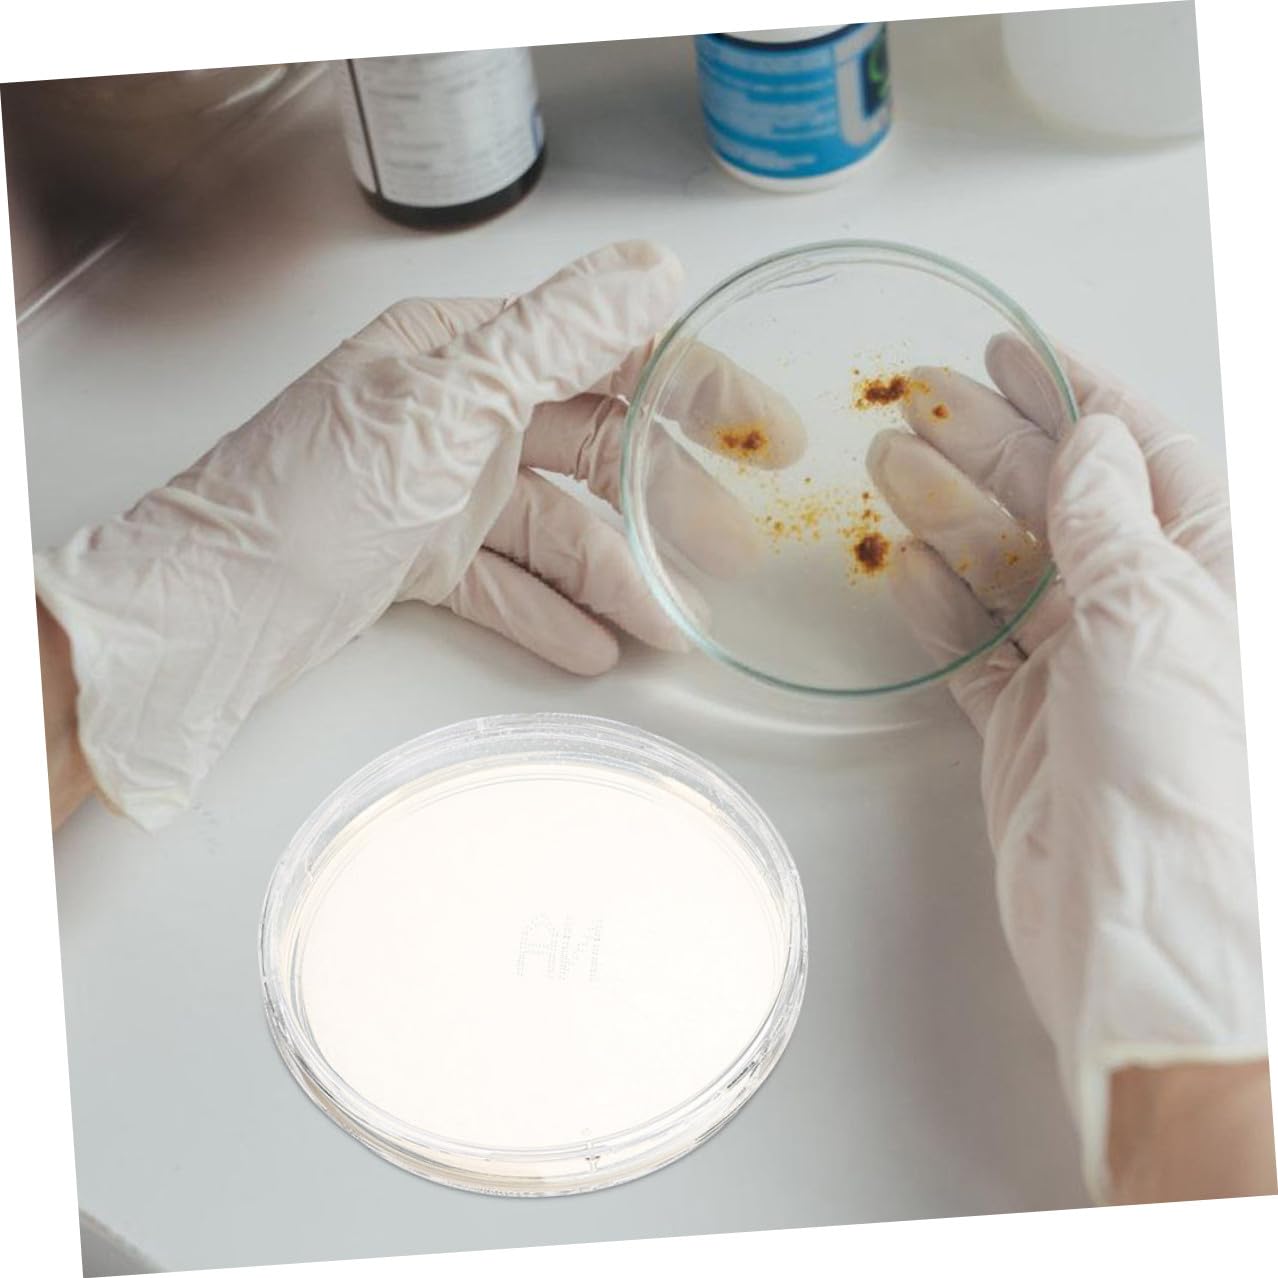

Cabilock 10pcs Nutrient Agar Petri Dishes 6cm Round Prepoured Culture Plates for Laboratory Cell Culture and Science Experiments
 Limited Time Sale
Limited Time Sale$54.00 cheaper than the new price!!
Free cash-on-delivery fees for purchases over $99
Product details
| Management number | 211014097 | Release Date | 2026/04/04 | List Price | $36.00 | Model Number | 211014097 | ||
|---|---|---|---|---|---|---|---|---|---|
| Category | |||||||||
Package Include 10 x Nutritional Agar Plates Characteristics -Product Info: Nutrient agar plates -Size:6.00X6.00X2.00cm/2.36X2.36X0.79in -Nutrient-rich: contains a wealth of nutrients to meet the needs of cultivation, ensuring optimal growth conditions school science projects -Material:Agar -Durable: made from durable materials to ensure stable and reliable product quality, providing consistent results in your experiments -Versatile applications: suitable for cultivation, screening, and laboratory research, a wide range of uses in scientific studies research petri dishes -Easy to use: designed in a convenient plate shape, making it easy to carry and use in various laboratory settings and research projects science experiment supplies -Color:Multi -Reliable: testing to ensure the reliability and accuracy of the product, giving you confidence in your experimental outcomes petri plateGoods Descriptionculture dish Ideal for laboratory experiments, science projects, and industrial applications, they provide a dependable medium for research and educational purposes.agar plate These nutrient agar plates are designed for cultivating with precision and reliability.science plates Featuring a clear, round design, they allow for easy observation of growth
- Rich in nutrients: packed with essential nutrients to support the growth and development , ideal for various scientific experiments,lab themed parties,plates for laboratory use
- Easy to use: the plate design is convenient for handling and use, making it an for both professional and educational laboratory environments,petri agar plates,research petri dishes
- Reliable performance: undergoes rigorous quality control and testing to ensure the product's reliability and precision, giving you confidence in your research outcomes,laboratory science experiments,laboratory plates
- Durable quality: manufactured from durable materials to with the product's stability and reliability, delivering consistent experimental results,science projects tool,agar plates for experiment
- Versatile: suitable for culture, isolation, and laboratory research, a wide range of applications in scientific studies,agar plate,culture plate
| Item Weight | 10.6 ounces |
|---|---|
| Manufacturer | Cabilock |
| Item model number | S90SA131413O6BH |
| Product Dimensions | 2.36 x 2.36 x 0.79 inches |
Correction of product information
If you notice any omissions or errors in the product information on this page, please use the correction request form below.
Correction Request Form